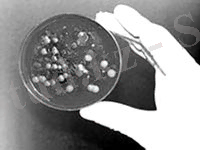

Возрождение аралы: биологиялық қарулар қалдықтары және Арал өңірінің экологиялық-эпидемиологиялық қатері


Жұмыс түрі: Материал
Тегін: Антиплагиат
Көлемі: 10 бет
Таңдаулыға:
Биологиялық лаңкестiк: қорқыныш, қайғы
Зұлымдық қаруының тамыры тереңде
 Мұнан бiрнеше жыл бұрын әлемнiң аяқ астынан дүрлiккенi есiмiзде. Түйнеме дертi АҚШ-тың әр түкпiрiнде - Флоридада, Невадада, Нью-Йоркте - қатарынан бiрнеше адамды аурухана төсегiне таңды. Тек американдықтар емес, Австралия, Англия, Бельгия, Австрия, Израиль секiлдi басқа да көптеген елдердiң тұрғындары мазасызданып, үрейлендi. Мамандар «түйнеме қоздырғышының талауы - террористiк актiнiң салдары» дегендi айтты. Тiптi АҚШ-тың бұқаралық ақпарат құралдары американдықтарды дүрлiктiрген «түйнеме қоздырғышының Отаны - Қазақстан-мыс» деген жорамал таратты да. «Рейтер» агенттiгiнiң хабарлауынша, «Қазақстандағы бұрынғы кеңестiк армияның биологиялық қарулар сақтаған қоймаларын тексерген инспекторлар түйнеме қоздырғыштарының қорын тауыпты». Ал, жорамалдаушылар «осы қордың бiр бөлiгi қазақстандық қылмыстық топтар арқылы террористердiң қолына түскен болуы мүмкiн» деп есептейдi. Iле-шала қазақстандық органдар бұл жорамалды жоққа шығарып, мәлiмдеме жасады.
Мұнан бiрнеше жыл бұрын әлемнiң аяқ астынан дүрлiккенi есiмiзде. Түйнеме дертi АҚШ-тың әр түкпiрiнде - Флоридада, Невадада, Нью-Йоркте - қатарынан бiрнеше адамды аурухана төсегiне таңды. Тек американдықтар емес, Австралия, Англия, Бельгия, Австрия, Израиль секiлдi басқа да көптеген елдердiң тұрғындары мазасызданып, үрейлендi. Мамандар «түйнеме қоздырғышының талауы - террористiк актiнiң салдары» дегендi айтты. Тiптi АҚШ-тың бұқаралық ақпарат құралдары американдықтарды дүрлiктiрген «түйнеме қоздырғышының Отаны - Қазақстан-мыс» деген жорамал таратты да. «Рейтер» агенттiгiнiң хабарлауынша, «Қазақстандағы бұрынғы кеңестiк армияның биологиялық қарулар сақтаған қоймаларын тексерген инспекторлар түйнеме қоздырғыштарының қорын тауыпты». Ал, жорамалдаушылар «осы қордың бiр бөлiгi қазақстандық қылмыстық топтар арқылы террористердiң қолына түскен болуы мүмкiн» деп есептейдi. Iле-шала қазақстандық органдар бұл жорамалды жоққа шығарып, мәлiмдеме жасады.
Мұнан бұрын бiрер рет «Қазақстанда жасырын сақтаулы бактериологиялық қару бар екендiгi» туралы шу шыққан едi. Оны қоздырушының бiрi - экс-премьер Әкежан Қажыгелдин. Ол Вашингтонда «Қазақстан ядролық, химиялық және биологиялық қару өндiрiсi көздерiн сақтап қалып отыр. Қаржы тапшылығы шешiлген жағдайда, бұл өндiрiс орындарының жұмысын жолға қоюдың мүмкiндiгi бар» деп мәлiмдеме жасады. Демек, тағы да бiреулердiң жағдайды пайдаланып қалуға тырысуы жақсылық емес. Өйткенi, бiз ядролық жарылыстардан аз қасiрет шеккен жоқпыз.
 Ал, Арал теңiзiндегi Барсакелместiң қауiптi орындардың бiрi екендiгi жөнiнде бүгiнге дейiн мардымды ештеңе естiгенiмiз жоқ. КСРО басшылығы биологиялық қаруды қолдануға, жетiлдiруге тыйым салатын халықаралық құжаттарға қол қойғанымен, iс жүзiнде бактериологиялық қару-жарақты жетiлдiру жолдарын тоқтатқан емес. Бұл iске елуден аса ғылыми институттары, Ғылым академиясына қарасты «Биопрепарат» кешенi, бiрнеше өндiрiс орындары жұмылдырылды. Ал, американдық институт бақылаушыларының айтуынша, «Барсакелмес аралында биологиялық қаруды сынау жұмыстары 50 жыл бойы жүргiзiлген. Мұнда түйнеме, оба және бруцеллез қоздырғыштары салынған болат контейнерлер көмулi» көрiнедi. Мамандардың пiкiрiнше, табиғаттың өзi жаратқан вирустардай емес, арнаулы лабораторияда дүниеге келген, генетикалық жағынан күнделiктi өзгерiстерге ұшыраған бұл қауiптi микроағзаларды ауыздықтауға шамасы жететiн дәрi-дәрмектер жоқтың қасы. Ал, ең қорқыныштысы - қатерлi микроағзалар бiр кезде Барсакелмеске адам аяғы баспайтын түкпiр ретiнде қамалған болса, теңiз тартылуына орай жағдай басқаша. Демек, қауiптi аурулардың «бостандыққа» шығуы әбден ықтимал. Өйткенi, Барсакелместiң көлемi соңғы отыз жыл iшiнде он есе ұлғайып отыр.
Ал, Арал теңiзiндегi Барсакелместiң қауiптi орындардың бiрi екендiгi жөнiнде бүгiнге дейiн мардымды ештеңе естiгенiмiз жоқ. КСРО басшылығы биологиялық қаруды қолдануға, жетiлдiруге тыйым салатын халықаралық құжаттарға қол қойғанымен, iс жүзiнде бактериологиялық қару-жарақты жетiлдiру жолдарын тоқтатқан емес. Бұл iске елуден аса ғылыми институттары, Ғылым академиясына қарасты «Биопрепарат» кешенi, бiрнеше өндiрiс орындары жұмылдырылды. Ал, американдық институт бақылаушыларының айтуынша, «Барсакелмес аралында биологиялық қаруды сынау жұмыстары 50 жыл бойы жүргiзiлген. Мұнда түйнеме, оба және бруцеллез қоздырғыштары салынған болат контейнерлер көмулi» көрiнедi. Мамандардың пiкiрiнше, табиғаттың өзi жаратқан вирустардай емес, арнаулы лабораторияда дүниеге келген, генетикалық жағынан күнделiктi өзгерiстерге ұшыраған бұл қауiптi микроағзаларды ауыздықтауға шамасы жететiн дәрi-дәрмектер жоқтың қасы. Ал, ең қорқыныштысы - қатерлi микроағзалар бiр кезде Барсакелмеске адам аяғы баспайтын түкпiр ретiнде қамалған болса, теңiз тартылуына орай жағдай басқаша. Демек, қауiптi аурулардың «бостандыққа» шығуы әбден ықтимал. Өйткенi, Барсакелместiң көлемi соңғы отыз жыл iшiнде он есе ұлғайып отыр.
Мұнан сегiз жыл бұрын АҚШ-тан келген мамандар өткiзген арнайы тексеру кезiнде Барсакелмес топырағының құрамында да «тiрi» вирустардың бар екендiгi белгiлi болған. Оның аумағының үштен екiсi Өзбекстанға тиесiлi. Үштен бiрi ғана Қазақстандiкi. Әйтсе де, нақты шекара анықталған жоқ. Мұның өзi көп нәрселерге кедергi. Айтпақшы, соңғы жылдары Қазақстанда да, Өзбекстанда да оба дертiнiң бас көтеру фактiлерi тiркелгенi баршамызға белгiлi.
Жұқпалы ауру тарату - адамзат үшiн таңсық емес. Бұл амал микробиологияның iргесi қаланбастан бұрын қолданыла бастаған 1945 жылы Бостонда жарық көрген «Американдық үндiстердiң тағдырына шешектiң әсерi» деген кiтапта (автор - Э. В. Стерн, А. Э. Стерн) полковник Букэнiң шешекке шалдыққандар госпиталiнен алынған екi жамылғы мен басқа да заттарды арнайылап үндiстер көсемiне жолдағаны және осы оқиғадан кейiн сол маңдағы үндiстер арасында шешек iндетi белең алғандығы туралы айтылған. Дүниежүзiлiк соғыс кезiнде немiстердiң түйнеме қоздырғыштарын пайдаланғаны белгiлi. 1925 жылдың 17 маусымында әлемнiң 48 мемлекетi «Соғыс кезiнде тұншықтыратын улы және басқа газдар мен бактериологиялық құралдарды қолдануға тыйым салуға» қол қойды. Ал, оны қолданғандар қатарында АҚШ, Жапония сияқты iрi мемлекеттер болуы алаңдатарлық жағдай едi.
Жалпы, биотерроризм ежелгi қару екендiгiнде дау жоқ. Абайламаса, болмас. Тәңiрдiң өзi «сақтағанды сақтайды» емес пе? Кейбiр жайлар бiзге мұқият абай болу керектiгiн бiлдiредi.
Адамдар ажал аралында жүр
 Кеңестiк дәуiрдiң дүрiлдеп тұрған шағында «Возрождение» аралын ауызға алудан қорқатынбыз. Тiптi, оның үстiнен құс та ұшып өтпейтiн. Тәртiп солай. Ал, ендi, Қазақстан тәуелсiздiк тұғырына көтерiлген соң, тiлiмiз шығып айта бастадық. Құпия болып келген арал туралы, оның зардабы жайында қарлығаштай шырылдап, толғандық. Қанаттыға қақтырмай, тұмсықтыға шоқыттырмай тұрған әскерлер саясаттың салқын лебi сезiлiсiмен бiр-ақ күнде тастап шықты. Өйткенi олар, «көп қорқытады, терең батырады» дегендей бұқара арасында дендеп бара жатқан шындықтан қорықты. Тастап кеткен бұл аралдың құпиясы өте көп. Өйткенi, ешкiм де бактериологиялық қалдықтардың мұнда қоймасы жоқ деп айта алмайды. Абайламасақ, Арал теңiзi өңiрi - қазiр ажал аузында. Ешкiм бiзге, арал шежiресiн айтқан емес, қандай зардабы бар екендiгiнен бейхабармыз. Әскерилердiң жоқ болуы, тегiннен-тегiн емес. Мүмкiн «Возрождение» күндердiң күнiнде өзiнен-өзi жарылатын шығар, кiм бiлiптi?! Әрине «жаман айтпай жақсы жоқ» дегендi ұмытпағанымыз дұрыс. Сұмдықтың бетi әрмен болсын!?
Кеңестiк дәуiрдiң дүрiлдеп тұрған шағында «Возрождение» аралын ауызға алудан қорқатынбыз. Тiптi, оның үстiнен құс та ұшып өтпейтiн. Тәртiп солай. Ал, ендi, Қазақстан тәуелсiздiк тұғырына көтерiлген соң, тiлiмiз шығып айта бастадық. Құпия болып келген арал туралы, оның зардабы жайында қарлығаштай шырылдап, толғандық. Қанаттыға қақтырмай, тұмсықтыға шоқыттырмай тұрған әскерлер саясаттың салқын лебi сезiлiсiмен бiр-ақ күнде тастап шықты. Өйткенi олар, «көп қорқытады, терең батырады» дегендей бұқара арасында дендеп бара жатқан шындықтан қорықты. Тастап кеткен бұл аралдың құпиясы өте көп. Өйткенi, ешкiм де бактериологиялық қалдықтардың мұнда қоймасы жоқ деп айта алмайды. Абайламасақ, Арал теңiзi өңiрi - қазiр ажал аузында. Ешкiм бiзге, арал шежiресiн айтқан емес, қандай зардабы бар екендiгiнен бейхабармыз. Әскерилердiң жоқ болуы, тегiннен-тегiн емес. Мүмкiн «Возрождение» күндердiң күнiнде өзiнен-өзi жарылатын шығар, кiм бiлiптi?! Әрине «жаман айтпай жақсы жоқ» дегендi ұмытпағанымыз дұрыс. Сұмдықтың бетi әрмен болсын!?
Жасыратыны жоқ, осы уақытқа дейiн арал полигонында жүргiзiлген әр түрлi сынақ жұмыстарының бағыт-бағдарлары, олардың адамзат пен қоршаған ортаға тигiзер зардаптары толық анықталып, ғылыми тұрғыда зерделенген жоқ. Әу баста отаршылдық пиғылмен, арам ниетпен қоршалған Николай патша ағзамның есiмiн еншiлеген оның құпиясы өте тереңде екенi әмбеге аян. Сондықтан да «Возрождение» әлiге дейiн жұмбақ күйiнде тұр.
Қорқыныштысы, «қазақтың қасиеттi даласын қатерлi қауiп алаңына айналдырғанында». Тастанды жұмбақ арал ендi қазағымның соры болмасына кiм кепiл? Осылайша өзiмiз қазақбайшылап отырғанда, бұл арал тағдыры туралы мұхиттың арғы бетiндегi АҚШ үкiметi бiзге беймәлiм құпияны бiледi. Қазақтар басын өлiмге тiккенiмен, американдықтардың өмiр сүргiсi келедi. Аралдағы өлiм себетiн бактериялардың түлеуi әбден мүмкiн, сақтанбаса болмайды. «Нью-Йорк таймс» газетiнiң «Уланған арал. Өлiм себетiн бактериялар Азияның қауiптi түкпiрiнде өмiр сүруде» деуi тектен-тек емес. Сондықтан да «Возрождениеде» биологиялық қарулардың қалдықтары тонналап көмiлген, бұл - фактi. Дәлел, 1988 жылы Ресейдiң Свердловск қаласынан топалаң (сибирская язва) тиелген 24 вагон цистернаның келуi. Олар алдын ала дайындалған он бiр шұңқырға көмiлген. Қазiр шамамен 1-2 метр тереңдiкте жатыр . . .
Ғалымдардың пiкiрiнше, мұнда бактериялық қаруға жататын вирустардың көмбесi де бар, олар топырақта елу жылға дейiн өлмейдi екен.
Ең қорқыныштысы, «Возрождение» аралы айналасындағы судың толып, құрлықпен жалғаса түскендiгi . . . Осы сияқты күрделi мәселелер ҚР Парламентi мен Үкiметiнiң назарына ұсынылып, бiрнеше хаттар жолданды, БАҚ арқылы материалдар жарияланды. Бiрақ «баяғы жартас, сол жартас», ештеңе өзгерген жоқ, ешкiм де селт еткен жоқ.
Қанша дегенмен де аралдың дүние жүзi үшiн тәжiрибе жүргiзген полигон болғаны рас. Осы ретте келтiрiлген залалдарды байыппен зерделеу кiмнiң iсi? Әскерлерден соң сол өңiрдi егжей-тегжейлi сараптаудан, бақылаудан өткiзбей бейғамдық танытуымыздың сыры неде? Сiрә, осындай жайбасарлық сол аймақтың ғана емес бүкiл қазақтың соры болмаса неғылсын? Адамзат баласының амандығы үшiн сыры «жұмбақ аралды» арнайы тәуелсiз сарапшылар елегiнен өткiзуге не кедергi? Әйтеуiр сұрақ көп болғанымен, жауаптың жоқ болуы ауыр болып тұр.
Қанша дегенмен де аралдың дүние жүзi үшiн тәжiрибе жүргiзген полигон болғаны рас. Осы ретте келтiрiлген залалдарды байыппен зерделеу кiмнiң iсi? Әскерлерден соң сол өңiрдi егжей-тегжейлi сараптаудан, бақылаудан өткiзбей бейғамдық танытуымыздың сыры неде? Сiрә, осындай жайбасарлық сол аймақтың ғана емес бүкiл қазақтың соры болмаса неғылсын? Адамзат баласының амандығы үшiн сыры «жұмбақ аралды» арнайы тәуелсiз сарапшылар елегiнен өткiзуге не кедергi? Әйтеуiр сұрақ көп болғанымен, жауаптың жоқ болуы ауыр болып тұр.
Ендiгi үлкен мәселе: «Возрождениеде» мұртынан күлген миссионерлердiң көбейе түскендiгi. Оның қатары жұмыссыздықты желеу еткен осы өңiр қара домалақтарының санымен өсуде. Олар - темiр iздеушiлер. Ендi олар ажал айдањары iспеттес болған аралға қаймықпастан енiп, ақша жинаудың қарекет қамында жүр. Өйткенi, металл қалдықтары - бiлген кiсiге тұнып тұрған табыс көзi. Осы жолды кәсiп етiп құныққандарды жүрегiнiң түгi бар демеске амал жоқ. Бағалы темiрдi жинау, сату т. б. жұмыстармен айналысатын топ бiреу емес, бiрнешеу. Басқарып отырған кiсi жоғары жақта. Жең ұшынан жалғасқан сыбайлас қылмыстардың көрiнiсi дәл осы жерде. «Крышасы» мықты болған соң ешкiм де мән бермейдi. Мықтылардың жаны тәттi, мұнда ат iзiн салмайды. Делдалдары арқылы алдап, ақша көрсетiп, құлдарын жұмсап жүр. Құлдары - осы өңiрдiң тепсе темiр үзетiн жастары. Олардың елiнiң де, жерiнiң де, қала бердi өзiнiң де болашағын ойлауына мүмкiншiлiгi жоқ. Әзiрше, ең қажеттiсi - ақша. Сол құнығу тажал iспеттес, өзiне тартып барады.
Әншейiн жатқан тетiктi, қол күшiмен жұлып алғанда «көмдiк» деген қуыстан қара жыландай ысылдап зәрiн шашып, бактериологиялық у шыға келсе, қайтемiз? Дүние жүзi медицинасы өкпе қабынуының белгiсiз дертiмен қалай күресерiн бiлмей дал болған шақта бұл «аралдан» сырқат сыр берсе - оны ауыздықтау оңай болмас? Өйткенi, Сыр елi - дарқан қазақтың қанаты қатайған жерi, тарихи мекенi. Салт-дәстүрiмiздiң алтын ұясы, сыр шертер шежiресi. Қазақы үрдiсi кеңiнен сақталған өлке. Әрi, адам өсiмi де жоғары деңгейде.
Он бес жылдың беделiнде аралды тонап бiтуге таядық. Ендiгi қалғаны, айтсаң жаның шошитын - лабораториясы. Егер одан ызыңдаған үн шықса, бiткенiмiз. Бұл өңiрдiң күлi көкке ұшады, ажал аузындағы Арал деуiмiз де сондықтан.
Кезiнде бактериологиялық қарулардың сынақ полигоны болған жердiң қањары әлi де күштi. Әсiресе, баклабораторияның жұмысы жұмбақ. Кейбiр деректер бойынша мұнда роботтық басқару жүйесi болыпты. Бұл жерде жұмыс iстеген мамандар радиациялық залалдан қорғайтын арнаулы киiмдер киген. Ал, темiр ұрлайтын қазақ жастары өңi түгiлi, түсiнде көрмеген «химзащита» киiмдерiн қайдан пайдалансын. Нартәуекел деп, не боларын ойламау - түбiнде жақсылыққа апарар жол емес.
Әскерилердiң заңы - бұйрық. Сол бұйрықты қайткенде, өлсе де орындау - мiндет. Олардың үдере көшуi - осы бұйрықтың арқасы. Ал, ол бұйрықта не жазылғанын, ешкiм бiлмейдi, әрине бiлуге тиiс те емес. Олай болса, әскерилердiң артына ешқашан айғақ тастамайтыны ақиқат. Құлқынның құлы болған жастарымыздың алып жатқаны (әрине ұрлап) - «зардапты қазына» ма деп те ойлайсың?
«Жау жоқ деме, жар астында». Демек, темiрге қол салып, жұмбақ аралдың iшiн қыдырып жүргендей емiн-еркiн аралау бүлдiршiнге - қауiптi. Ол қаншама бет бақтырмағанымен, түбiнде сырқатқа ұшырары анық. Қазақы әдет - «ауруын жасырған өледi», бiрақ пәтшағарлар айтпайды ғой. Кезiнде Қызылорда облысынан бұйрықпен Украинадағы Чернобыль апатына аттанғандар саны жүздеп саналса, қазiргi уақытта өмiр сүрiп жатқаны бiрлi-жарым ғана. Тiрiлердiң өзi - мүгедек. Мiне, көзге көрiнбейтiн радиацияның әсерi бұл. «Осы аралда радиация жоқ!» деп кiм кепiлдiк бере алады? Темiр терiмiндегi бозбалаң - сырқатты өзгелерге жұқтырушы боларына дау жоқ. «Ауру батпандап кiрiп, мысқалдап шығады». Экологиялық апат аймағы болып, Қызылорда қан түкiрiп, өкпе ауруы дендеген шақта, өзiмiзге бекем болмасақ қиын. Таудай табыс iздегендер бактерия бұлты арасында жүрiп, микробтарын сау аймаққа әкелiп таратып жатса ше? Өйткенi, полигонда сарып, оба, шешек, безгек ауруларын қоздырғыш бактериялар сыналды ғой?!
 Жалпы, «Возрождение» аралында темiр iздеушiлердiң денi, Оңтүстiк Қазақстан, Қызылорда, Ақтөбе, Жамбыл облыстары мен Байқоңыр қаласынан. Осыдан-ақ бактерияның таралу аймағы белгiлi.
Жалпы, «Возрождение» аралында темiр iздеушiлердiң денi, Оңтүстiк Қазақстан, Қызылорда, Ақтөбе, Жамбыл облыстары мен Байқоңыр қаласынан. Осыдан-ақ бактерияның таралу аймағы белгiлi.
ОСЫ ОРАЙДА АЙТА КЕТЕТIН БIР МӘСЕЛЕ, ОЛ - ОСЫ УАҚЫТҚА ДЕЙIН ӘСКЕРИ АРАЛДАН АТТАНҒАН МҮЛIКТЕР МЕН ТЕХНИКАЛАРДЫҢ, ТОННАЛАҒАН МЕТАЛЛ ҚАЛДЫҚТАРЫНЫҢ ЖАН-ЖАҚҚА ТАРАП КЕТКЕНДIГI МӘЛIМ. ЖҮРЕКТI СОЛҚ ЕТКIЗЕР ЖАЙСЫЗ ЖАҒДАЙ «ТЕМIР ТАБЫТТАРДЫҢ» КҮНДЕРДIҢ КҮНIНДЕ СЫР БЕРЕРI КҮДIК ШЫҒАР. БIЗ ОСЫНЫ ОЙЛАДЫҚ ПА? ӘЙ, ҚАЙДАМ? ЕҢ НЕГIЗГIСI, ОЛ - БИОЛОГИЯЛЫҚ ҚАРУДЫҢ АУРУ ТУҒЫЗАТЫН ФАКТОРЛАРЫ МИКРООРГАНИЗМДЕР МЕН КЕМIРГIШ ЖӘНДIКТЕР.
Өзектi мәселенiң оймақтай түйiнi
Тоқсан ауыз сөздiң қорытындысы! Өзбек болып, қарақалпақ болып жұмылып жұмбақ аралға бекем болмасақ жағдай ушыққалы тұр. Байғұс қазақтың даңғазалығы басым, кейде қызыңқырап кететiн жағдайы тағы бар. Талан-таражға түскен жыланның улы тiлiндей темiрлер - бейғамдықтың соры. Алақандай аралға барушылардың жолдарына мықты тосқауыл қойылмаса, бақылау күшейтiлмесе қасiретке тап болармыз. Кейбiреулердiң «бағым» деп аттанған сапары - соңғы сапары болмасын. Олай болса, айналайын ағайын, ажалдан аулақ жүргенiң абзал! Сынақ полигоны болған арал - қазiр қауiптi аймақ. Осы ретте шешiмiн таппай жүрген Кеңестер Одағынан қалған «мұра» бюрократтықтың тамыры жұлынбай осы кезге жетуi де қасiреттi дерт. Осындай дерттер асқынып кетпесе жарар едi?
ЕЛ ТӘУЕЛСIЗДIК АЛДЫ, ҚАЗАҚ өСТI, БАЙЫДЫ, ЖЕТIЛДI. БИЛIК ТЕ өЗIНДЕ. АҚШАСЫ ДА - АЛАҚАНЫНДА. «ОРТ-ҒА» РЕСЕЙДIҢ ПРЕМЬЕР-МИНИСТРI ШЫҚСА, ТIЛIП-ТIЛIП СөЙЛЕЙДI, МӘСЕЛЕНI ЗАМАТЫНДА ШЕШЕДI. АЛ, БIЗДIҢ ПРЕМЬЕР-МИНИСТРIМIЗ ДАНИАЛ АХМЕТОВ МЫРЗА ШЕ? АРАЛ ПРОБЛЕМАСЫ - ДҮНИЕЖҮЗIЛIК ПРОБЛЕМАҒА АЙНАЛЫП ТҰРҒАНДА ЖАҚ АШПАЙДЫ-АЙ?! ТIПТI, БIРШАМА УАҚЫТ БҰРЫН АПАТ АЙМАҒЫ МӘРТЕБЕСIН АЛЫП ТАСТАУ КЕРЕК ДЕП БIР ДҮРЛIКТIК. ЖАСЫРАТЫНЫ ЖОҚ, ҚОШТАҒАНДАР ДА ТАБЫЛДЫ. АЛ АЖАЛ АРАЛЫНДА ЖҮРГЕН АДАМДАР МЕН СОЛ МАҢДАҒЫ ЕЛ ТАҒДЫРЫ ШЕНЕУНIК МЫРЗАЛАРДЫ ОЙЛАНДЫРСА ИГI?!
Нашақорлық - жұлын құрты,
онымен қоғам болып күресу қажет
Қазiргi күнi нашақорлық пен есiрткi бизнесiне қарсы күрес мәселесi өзiнiң көкейкестiлiгiн жоғалтпай келе жатқаны баршаға аян. Бұл қоғамдық кеселдiң алдын алу, оны болдырмау мақсатында мемлекеттiк бағдарламалар қабылданып, кешендi iс-шаралар жүзеге асырылуда. Бұл тұрғыда ҚР IIМ-нiң Есiрткi бизнесiне қарсы күрес және есiрткiнiң заңсыз айналымына бақылау жасау комитетi мен оның бөлiмшелерiнiң атқарып келе жатқан iстерi ауыз толтырып айтарлықтай. Осы мақсатта арнайы бөлiмше қызметкерлерi тұрғындардың арасында түрлi профилактикалық шараларды өткiзiп келедi. Олардың санасында есiрткiге қарсылық сезiмiн туғызу, нашақорлық өсiмiне қарсы күрес мәселесiндегi түрлi қоғамдық және мемлекеттiк ұйымдардың iс-әрекетiне бағыт-бағдар беруде де атқарылып жатқан жұмыстар орасан.
 Аздап цифрларға жүгiнсек, 2004 жылы Астана қаласында есiрткi заттарын пайдаланатын 875 адам арнайы есепте тұрса, 2005 жылдың басында олардың саны 1028 адамға жеттi. Алкогольдi iшiмдiктер, есiрткi және психотропты заттарды шектен тыс пайдаланатын 115 жеткiншек Астана қаласы IIД есепте тұр, оның iшiнде 11 кәмелетке толмаған жаста «нашақор» диагнозы, бiреуiнде «маскүнем», ал 92-сi «токсикоман» диагнозымен тiркеуде тұрғандар.
Аздап цифрларға жүгiнсек, 2004 жылы Астана қаласында есiрткi заттарын пайдаланатын 875 адам арнайы есепте тұрса, 2005 жылдың басында олардың саны 1028 адамға жеттi. Алкогольдi iшiмдiктер, есiрткi және психотропты заттарды шектен тыс пайдаланатын 115 жеткiншек Астана қаласы IIД есепте тұр, оның iшiнде 11 кәмелетке толмаған жаста «нашақор» диагнозы, бiреуiнде «маскүнем», ал 92-сi «токсикоман» диагнозымен тiркеуде тұрғандар.
Осы тәрiздес келеңсiздiктердiң алдын алу мақсатында Есiрткi бизнесiне қарсы күрес және есiрткiнiң заңсыз айналымына бақылау жасау комитетi мен Астана қаласы IIД алдын алу және қоғамдық байланыстар бөлiмiнiң қызметкерлерi Астана қаласы Дәрiгерлiк-әлеуметтiк сауықтыру орталығымен бiрлесiп, мектептер мен жоғары оқу орындарында түрлi лекциялар, дөңгелек үстелдер, пiкiрталастар ұйымдастырып отырады. Атап айтар болсақ, жыл басынан берi қаладағы жалпы бiлiм беру мекемелерi, Басқару институты, Президенттiң Мәдени орталығы, Л. Гумилев атындағы Еуразия Ұлттық университетi және т. б. мекемелерде «Есiрткiсiз өмiр», «Қазақстан Республикасындағы есiрткi ахуалы», «Жастар есiрткiге қарсы» сынды девиздермен сан-салалы iс-шаралар өткiзiлдi.
Мәселен, қаңтар айында бiздiң қызметкерлер балалардың спорт мектебiнде спорт жарыстарын ұйымдастырды. Мамыр айында Балаларды қорғау күнiне орай қала аумағында түрлi сайыстар, концерттiк бағдарламалар, асфальттағы балалар суретi конкурстары, «Веселые старты» жарыстары өткiзiлдi. Сондай-ақ, №2 және №9 мектептерде, Балалар үйiнде, кәмелетке толмағандарды уақытша оқшаулау, бейiмдеу және оңалту орталығында есiрткiге қарсы үгiт-насихат шаралары болып өттi.
9-12 наурызда комитет Мәдениет, ақпарат және спорт министрлiгiнiң Спорт комитетiмен бiрлесiп «Спорт - есiрткiге қарсы» девизiмен хоккейден «Жұлдызша» республикалық сайысын ұйымдастырып, өткiздi. Оған 1994-1995 жылы туған жасөспiрiмдер қатысты.
19-20 ақпанда Астана қалалық Мәдениет және демалыс саябағында «Туризм - есiрткiге қарсы» ұранымен «Фестина» турист клубының Кубогы үшiн шаңғы туризмi техникасы бойынша жарыстар болып өттi. Сайыстар нәтижелерi бойынша, үздiк шыққан республикамыздың әр аймағынан келген үш команда комитеттiң грамоталары мен бағалы сыйлықтарына ие болды.
Сонымен қатар, комитет басшылығы БАҚ арқылы тұрғындарда есiрткiге қарсы иммунитеттi қалыптастыру мәселесiне көп көңiл бөледi. Осы мақсатта елiмiздегi барлық дерлiк БАҚ-мен тығыз iскерлiк байланыс орнатылып, қарқынды жұмыстар жүзеге асырылуда. Осы сөзiмiзге дәлел ретiнде, мамыр айында комитет қызметкерлерi мен БАҚ өкiлдерiнен құралған делегация Астана қаласынан 220 шақырымда Ерейментау ауданында орналасқан «Батыр» турист лагерiнде болып, «Туризм - денсаулық кепiлi» деп аталатын акцияға қатысты. Акция барысында, жас туристер журналистер қауымына өз өнерлерiн көрсетiп, тауға өрмелеу, шатыр құру сынды бәсекелерде жарыстар ұйымдастырды.
Сандарға жүгiнсек, 2005 жылдың бес айында Астана қаласының өзiнде есiрткiге қатысты 83 қылмыс тiркелдi. Өткен жылдың осы кезеңiнде олардың саны 95-ке жеткен едi. Сондай-ақ, 70 қылмыстық iс қозғалды (өткен жылы 55), оның бiреуi шетел азаматына қатысты. Заңсыз айналымнан 4 келi 989, 73 грамм есiрткi (өткен жылы 50 келi 285, 139), оның iшiнде 231, 82 грамм героин тәркiлендi.
ҚР IIМ Есiрткi бизнесiне қарсы күрес және есiрткi айналымына бақылау жасау комитетi мен Астана қаласы IIД Есiрткi бизнесiне қарсы күрес басқармасы қызметкерлерiнiң тыңғылықтылығының арқасында 32 есiрткi таратушының жолы кесiлдi. Осы кезеңде Астана қаласында «Допинг» жедел алдын алу iс-шарасының 2 сатысы ұйымдастырылды. Аталмыш операция барысында, медицина қызметкерлерiнiң есiрткi заттар мен психотропты заттар, прекурсорларды сатып алу, сақтау, тiркеу, беру және жою ережелерiн бұзу оқиғаларының алдын алу мақсатында дәрiханалар, өндiрiс кәсiпорындары мен емдеу алдын алу мекемелерiне жоспарлы және жоспардан тыс тексерiстер ұйымдастырды.
Тағы бiр айта кетер мәселе, Астана аумағына есiрткi заттарының келуiне тосқауыл қою екенi баршаға аян. Осы мақсатта комитет Астана қаласы IIД қызығушылық танытқан қызметкерлерiмен бiрлесiп, арнайы iс-шаралардың жоспарын жасап, жүзеге асырып келедi. Оның барысында, арнайы иiсшiл иттердi пайдалану арқылы «Рубеж» қоршау жүйелерi бекеттерi арқылы өтетiн Тәжiкстан, Ресей, Өзбекстанның мемлекеттiк нөмiрлi автокөлiктерi мен халықаралық бағыттардағы жолаушы тасымалдау автобустарына тексерiстер жүргiзiледi. Мәселен, жуырда «Қызылжар» бекетi орналасқан «Алматы-Қарағанды-Астана» тас жолында күдiк туғызған азаматтан 65, 86 грамм героин табылып, тәркiлендi. Қазiр аталмыш фактi бойынша тергеу амалдары жүргiзiлуде.
Қаламыз астана мәртебесiне ие болғалы, мұнда түрлi түнгi клубтар мен дәмхана-мейрамханалардың жаңбырдан кейiнгi саңырауқұлақтай қаптап кеткенiн баршамыз бiлемiз. Жастар жиналатын жерде темекi мен арақтың, ақшаның судай шашылатыны да баршаға аян. Бiр түн болса да, армансыз бiр демалып, билеп, ойнап-күлiп қайтуды арман еткен жастарды түрлi жымысқы ойлы элементтердiң айналсоқтап жүретiнi де шындық. Олар онсыз да жеңiлтек жастарды есiрткi заттарға отырғызуды алдына мақсат еткен арам пиғылды адамдар.
 Осылардың жолына тосқауыл болу, нашақорлар санын азайту, түп-тамырымен жою мақсатында Есiрткi бизнесiне қарсы күрес бөлiмшелерi дамылсыз жұмыс атқаруда. Бұл бағытта комитет қызметкерлерi астаналық полицейлермен бiрлесiп, әр түнгi клубта жасырын тексерiстер мен бақылауларды жүзеге асырады.
Осылардың жолына тосқауыл болу, нашақорлар санын азайту, түп-тамырымен жою мақсатында Есiрткi бизнесiне қарсы күрес бөлiмшелерi дамылсыз жұмыс атқаруда. Бұл бағытта комитет қызметкерлерi астаналық полицейлермен бiрлесiп, әр түнгi клубта жасырын тексерiстер мен бақылауларды жүзеге асырады.
Қазiргi күнi Астана қаласында 133 көңiл-көтеру мекемесi болса, оның 17-сi жастарды топтап жинайтын түнгi клубтар. Жуырда осы түнгi клубтардың бiрнешеуiне арнайы тексерiстер жүргiзген астаналық полицейлер олардың екеуiнен марихуана есiрткi затын қолданған екi жасты қолға түсiрдi. Оларға қатысты ҚР ӘҚБ Кодексiнiң 320-бабы бойынша әкiмшiлiк жауапкершiлiкке тартылды. Қазiргi күнi аталмыш клуб әкiмшiлiгiн ҚР ӘҚБ Кодексiнiң 319-бабы бойынша жазалау мәселесi қарастырылуда.
Бұл айтылғандар, ҚР IIМ Есiрткi бизнесiне қарсы күрес және есiрткiнiң айналымына бақылау жасау комитетiнiң атқарып келе жатқан жұмыстарының бiр көрiнiсi ғана. Бұл бағыттағы жұмыстар одан әрi жалғасын тауып отыратынына сенiмiм кәмiл.
... жалғасы- Іс жүргізу
- Автоматтандыру, Техника
- Алғашқы әскери дайындық
- Астрономия
- Ауыл шаруашылығы
- Банк ісі
- Бизнесті бағалау
- Биология
- Бухгалтерлік іс
- Валеология
- Ветеринария
- География
- Геология, Геофизика, Геодезия
- Дін
- Ет, сүт, шарап өнімдері
- Жалпы тарих
- Жер кадастрі, Жылжымайтын мүлік
- Журналистика
- Информатика
- Кеден ісі
- Маркетинг
- Математика, Геометрия
- Медицина
- Мемлекеттік басқару
- Менеджмент
- Мұнай, Газ
- Мұрағат ісі
- Мәдениеттану
- ОБЖ (Основы безопасности жизнедеятельности)
- Педагогика
- Полиграфия
- Психология
- Салық
- Саясаттану
- Сақтандыру
- Сертификаттау, стандарттау
- Социология, Демография
- Спорт
- Статистика
- Тілтану, Филология
- Тарихи тұлғалар
- Тау-кен ісі
- Транспорт
- Туризм
- Физика
- Философия
- Халықаралық қатынастар
- Химия
- Экология, Қоршаған ортаны қорғау
- Экономика
- Экономикалық география
- Электротехника
- Қазақстан тарихы
- Қаржы
- Құрылыс
- Құқық, Криминалистика
- Әдебиет
- Өнер, музыка
- Өнеркәсіп, Өндіріс
Қазақ тілінде жазылған рефераттар, курстық жұмыстар, дипломдық жұмыстар бойынша біздің қор #1 болып табылады.



Ақпарат
Қосымша
Email: info@stud.kz